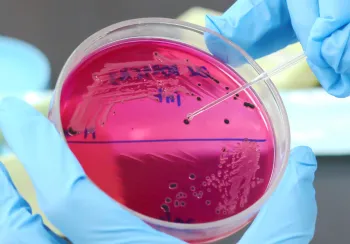
24 01 29 Ergebnisse Salmonellen Ringversuch

Im Jahr 2025 führte QS erneut den jährlichen Laborkompetenztest für das Salmonellenmonitoring (Schwein) durch. Insgesamt nahmen 26 Labore aus sieben Ländern – Deutschland, den Niederlanden, Luxemburg, der Schweiz, Polen, Ungarn und Irland – teil. Unter ihnen befanden sich 22 QS-anerkannte Labore sowie vier Drittlabore, die freiwillig am Test teilgenommen haben. Von den teilnehmenden Laboren konnten 22 den Test erfolgreich bestehen. Bei vier Laboren kam es zu einer zu hohen Anzahl an Quantifizierungsfehlern, sodass diese den Test nicht erfolgreich abschließen konnten. Drei dieser Labore sind im QS-Salmonellenmonitoring Schwein anerkannt. Hier besteht Nachbesserungsbedarf.
Für den Test erhielten die Labore jeweils zehn lyophilisierte Fleischsaft- und Serumproben mit unterschiedlichen Gehalten an Salmonellenantikörpern, die innerhalb von 14 Tagen untersucht werden mussten. Ziel der jährlichen Überprüfung ist es, die Zuverlässigkeit und Genauigkeit der Analysen sicherzustellen, die eine wichtige Grundlage für das Salmonellenmonitoring in der Schweineproduktion bilden. Für QS-anerkannte Labore ist die Teilnahme am Laborkompetenztest verpflichtend und trägt maßgeblich zur Sicherung der Laborqualität sowie zur Verlässlichkeit des Monitoringsystems bei.